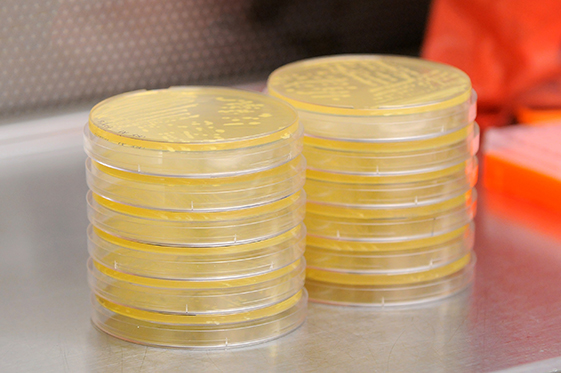
Building

菌种鉴定服务
金唯智为您提供细菌、真菌等微生物的菌种鉴定服务,通过扩增细菌16S rDNA或真菌18S rDNA、ITS片段进而测序,并与NCBI数据库比对,以达到分类鉴定的目的。您仅需提供待鉴定样品,我们将在最短时间提供包含全面种属特异性信息的检测结果给您。咨询,请点击
服务类型
16S rDNA部分序列分析
ITS全序列分析
26S rDNA D1/ D2 区序列分析
16S rDNA全序列分析
18S rDNA全序列分析
菌种鉴定服务参数
- <24个样品,7-9个工作日
- 其他咨询
- PCR产物电泳图
- PCR产物测序结果
- blast结果
- 实验报告
| 送样要求 | 服务周期 | 交付结果 |
|
基因组DNA:浓度≥50 ng/μl, |
|
|
服务优势
具有竞争力的价格
高质量&免费的通用引物
专业的技术支持及资深的项目管理
全程为您解决任何技术与服务疑问,定时更新您的项目信息、及时追踪您的项目进展
全程为您解决任何技术与服务疑问,定时更新您的项目信息、及时追踪您的项目进展
服务优势
具有竞争力的价格
高质量&免费的通用引物
专业的技术支持及资深的项目管理
全程为您解决任何技术与服务疑问,定时更新您的项目信息、及时追踪您的项目进展
全程为您解决任何技术与服务疑问,定时更新您的项目信息、及时追踪您的项目进展
科学的检测流程和精确的检测结果
专业的技术支持及资深的项目管理
全程为您解决任何技术与服务疑问,定时更新您的项目信息、及时追踪您的项目进展
全程为您解决任何技术与服务疑问,定时更新您的项目信息、及时追踪您的项目进展




















































